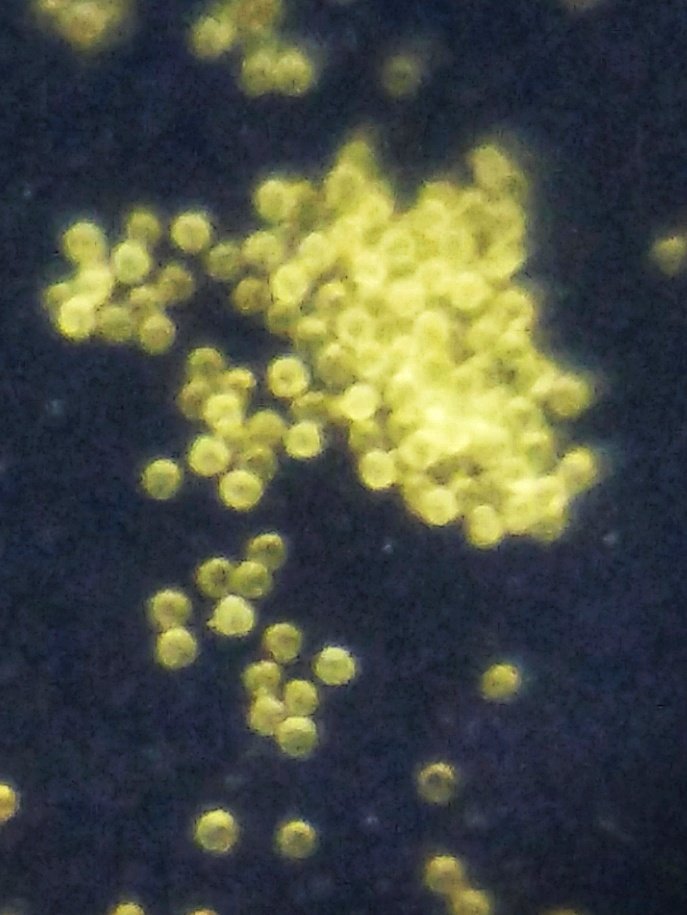

불로화
"오늘의AI위키"의 AI를 통해 더욱 풍부하고 폭넓은 지식 경험을 누리세요.
1. 개요
불로화(Ageratum houstonianum)는 국화과의 한해살이풀 또는 왜성 관목으로, 관상용으로 널리 재배된다. 중앙 아메리카가 원산지이며, 현재는 전 세계 열대 및 아열대 지역에 귀화하여 분포한다. 불로화는 메토프렌 유사 화합물을 생성하여 곤충의 성장을 방해하며, 피롤리지딘 알칼로이드를 함유하여 가축에게 독성을 나타낼 수 있다. 다양한 색상과 크기의 품종이 개발되었으며, 일부 품종은 왕립원예학회의 가든 메리트 상을 수상했다. 자연 서식지 밖에서는 잡초로 번질 위험이 있다.
더 읽어볼만한 페이지
- 등골나물족 - 스테비아
스테비아는 남아메리카 원산의 국화과 식물로, 스테비오사이드 성분 덕분에 천연 감미료로 사용되며 설탕보다 훨씬 단맛이 강하고 혈당 조절에도 도움을 줄 수 있어 식품 및 음료의 설탕 대체재로 활용된다. - 등골나물족 - 서양등골나물
서양등골나물은 북아메리카 원산의 여러해살이풀로, 관상용으로 재배되며 흰색 또는 연한 분홍색 꽃이 피고, 일본에서는 생태계를 위협하는 외래종이며, 피롤리지딘 알칼로이드와 트레메톨 같은 독성 물질을 함유하여 섭취 시 유해할 수 있다. - 1768년 기재된 식물 - 사과나무
사과나무는 동아시아 원산의 장미과 낙엽성 활엽 소교목으로, 전 세계에서 재배되며 흰색 또는 연분홍색 꽃을 피우고 달콤하고 새콤한 맛의 사과 열매를 맺으며 목재로도 활용된다. - 1768년 기재된 식물 - 알레포소나무
알레포소나무는 지중해 연안에 자생하며 붉은 나무껍질과 얇은 잎을 가진 6~25m 크기의 침엽수로, 방풍림 조성이나 레치나 와인 향료로 쓰이나 일부 지역에서는 외래종으로 생태계에 영향을 준다. - 원예 식물 - 석류나무
석류나무는 서남아시아와 중동 원산의 부처꽃과 낙엽성 소교목으로, 붉은 꽃과 식용 열매가 특징이며, 풍요와 다산의 상징으로 여겨져 왔고 전통 의학 및 염색 등 다양한 용도로 활용된다. - 원예 식물 - 국화속
국화속(Chrysanthemum)은 관상용 여러해살이풀로 두상화 형태의 꽃을 피우며, 다양한 색상과 크기를 가지고 동아시아 문화에서 중요한 의미를 지닌다.
| 불로화 - [생물]에 관한 문서 | |
|---|---|
| 기본 정보 | |
![]() | |
| 학명 | Ageratum houstonianum |
| 명명자 | Mill. |
| 이명 | Ageratum mexicanum Sweet Ageratum mexicanum Sims Ageratum wendlandii Hort. ex Vilm. Ageratum wendlandii Bailly Cacalia mentrasto Vell. Carelia houstoniana (Mill.) Kuntze |
| 일반명 | 불로화 오오캇코우아자미 (オオカッコウアザミ) 무라사키캇코우아자미 (ムラサキカッコウアザミ) |
| 영어 이름 | Flossflower Bluemink |
| 설명 | 다년생 식물 |
| 분류 | |
| 계 | 식물계 |
| 문 | 속씨식물군 |
| 강 | 진정쌍떡잎식물군 |
| 목 | 국화목 |
| 과 | 국화과 |
| 아과 | 국화아과 |
| 족 | 등골나물족 |
| 속 | 등골나물아재비속 |
2. 식물학적 특징
이 초본 한해살이풀 또는 왜성 관목은 높이가 0.3m 에서 1m까지 자란다. 잎은 난형 또는 삼각형 모양으로 길이는 2cm 에서 7cm이다. 꽃은 주로 파란색이지만 때로는 흰색, 분홍색, 보라색을 띠기도 하며, 빽빽한 산방꽃차례를 이룬다. 설상화는 실 모양이며 솜털이 있어 흔히 '솜털꽃'이라는 이름으로 불리기도 한다. 포는 좁은 피침형으로 뾰족하며, 윗부분에만 톱니 모양이 있고 선모가 있다. 이 식물은 나비를 유인한다.[6]
2. 1. 개화 시기
개화 기간은 북반구에서 5월부터 11월까지이다.[5]3. 분포 및 서식지
전 세계의 열대 및 아열대 지역에 널리 퍼져 귀화하였다. 특히 미국 남부, 호주, 유럽, 아프리카, 중국, 일본, 뉴질랜드, 필리핀 등 여러 나라에서는 침입성 잡초로 간주되기도 한다.[13] 한국에서도 귀화식물로 분류되며, 전국 각지에서 발견된다.
3. 1. 서식 환경
중앙 아메리카(과테말라, 벨리즈, 멕시코 인접 지역 포함)가 원산지이지만, 다른 지역에서는 침입성 잡초로 여겨지기도 한다. 열대 지역과 미국 남부 등에서도 귀화하여 자생하고 있다. 주로 해발 1000m까지의 목초지, 습한 숲의 빈터, 덤불 등에서 발견된다. 시원한 토양과 햇볕이 잘 드는 환경을 선호한다.4. 화학적 성분
불로화(Ageratum|아게라툼lat)는 곤충으로부터 자신을 보호하기 위해 독특한 화학 물질을 만들어낸다. 이 식물은 메토프렌과 유사한 화합물을 생성하는데, 이 화합물은 곤충의 성장과 발달 과정에서 유충 호르몬을 분비하는 기관인 황체의 정상적인 기능을 방해한다. 이 화학 물질은 곤충의 다음 탈피 주기를 앞당겨 성체 구조가 조기에 발달하도록 만들며, 곤충이 충분한 양을 섭취할 경우 대부분 불임 상태가 될 수 있다.[9]
4. 1. 독성
불로화(Ageratum|아게라툼lat)는 간에 병변을 일으켜 방목하는 동물을 중독시킬 수 있다.[10][11] 이는 피롤리지딘 알칼로이드를 함유하고 있기 때문이다.[12]5. 재배 및 관리
불로화는 여름 화단이나 발코니 상자용 관상 식물로 널리 이용되며, 키가 큰 품종은 절화로도 사용된다. 주로 일년생으로 재배되고, 꽃 색깔은 파란색, 보라색, 분홍색, 흰색 등 다양하다. 시원한 토양과 햇볕을 좋아하며, 키가 큰 품종은 60cm까지 자랄 수 있다.[7][8]
5. 1. 품종

불로화(''Ageratum houstonianum'')에는 다음과 같은 변종 및 품종형이 있다.
- ''Ageratum houstonianum'' var. ''angustatum'' B.L. Rob.[14]
- ''Ageratum houstonianum'' f. ''isochroum''
- ''Ageratum houstonianum'' f. ''luteum''
- ''Ageratum houstonianum'' var. ''muticescens''
- ''Ageratum houstonianum'' f. ''niveum''
- ''Ageratum houstonianum'' f. ''normale''
- ''Ageratum houstonianum'' var. ''typicum''
- ''Ageratum houstonianum'' f. ''versicolor''
재배 품종 중 '블루 다뉴브'[15]와 '블루 호라이즌'[16]은 왕립원예학회의 가든 메리트 상을 수상했다.[17]
6. 잡초 위험성
불로화(''애기족제비싸리'', Ageratum houstonianum)는 본래 과테말라와 벨리즈, 멕시코 인접 지역을 포함하는 중앙 아메리카가 원산지이다. 하지만 자연 서식지 밖에서 재배될 경우 급격하게 번식하여 잡초가 될 가능성이 높다.[13] 실제로 미국, 호주, 유럽, 아프리카, 중국, 일본, 뉴질랜드, 필리핀 등 여러 지역에서 침입성 잡초로 자리 잡았다.[13] 열대 지역과 미국 남부에서도 귀화하여 정착하였다. 주로 해발 1000m까지의 목초지, 습한 숲의 빈터, 덤불 등에서 서식한다.
7. 사진
참조
[1]
ThePlantList
[2]
웹사이트
"''Ageratum houstonianum'' (Ageratum, Blue Billygoatweed, Bluemink, Floss Flower, Mexican Ageratum)"
http://plants.ces.nc[...]
NC State Ag Extension
2021-05-15
[3]
웹사이트
"''Ageratum houstonianum''"
http://www.missourib[...]
Missouri Botanical Garden
2021-05-15
[4]
서적
Rothmaler - excursion flora of Germany. Volume 5: Herbaceous ornamental and useful plants
Spektrum Akademischer Verlag, Berlin Heidelberg
2008
[5]
웹사이트
New South Wales Flora Online, ''Ageratum houstonianum''
http://plantnet.rbgs[...]
[6]
웹사이트
Ageratum houstonianum - Plant Finder
https://www.missouri[...]
2021-12-20
[7]
eFloras
Ageratum houstonianum
[8]
웹사이트
Species profile
http://plantnet.rbgs[...]
[9]
간행물
Biological activity of precocene analogues on ''Locusta migratoria''
1988-09
[10]
서적
"Poisonous Plants and Related Toxins"
2004
[11]
간행물
"Ageratum houstonianum toxicosis in Zebu cattle"
2004
[12]
간행물
"Pyrrolizidine alkaloids from Ageratum houstonianum Mill."
https://www.ncbi.nlm[...]
2001-08
[13]
웹사이트
Global Compendium of Weeds, Ageratum houstonianum (Asteraceae)
http://www.hear.org/[...]
[14]
웹사이트
JSTOR Plant Science
http://plants.jstor.[...]
[15]
웹사이트
"''Ageratum houstoninum'' 'Blue Danube'"
https://www.rhs.org.[...]
RHS
2020-02-27
[16]
웹사이트
"''Ageratum houstonianum'' 'Blue Horizon'"
https://www.rhs.org.[...]
RHS
2020-02-27
[17]
웹사이트
AGM Plants - Ornamental
https://www.rhs.org.[...]
Royal Horticultural Society
2018-11
본 사이트는 AI가 위키백과와 뉴스 기사,정부 간행물,학술 논문등을 바탕으로 정보를 가공하여 제공하는 백과사전형 서비스입니다.
모든 문서는 AI에 의해 자동 생성되며, CC BY-SA 4.0 라이선스에 따라 이용할 수 있습니다.
하지만, 위키백과나 뉴스 기사 자체에 오류, 부정확한 정보, 또는 가짜 뉴스가 포함될 수 있으며, AI는 이러한 내용을 완벽하게 걸러내지 못할 수 있습니다.
따라서 제공되는 정보에 일부 오류나 편향이 있을 수 있으므로, 중요한 정보는 반드시 다른 출처를 통해 교차 검증하시기 바랍니다.
문의하기 : help@durumis.com
